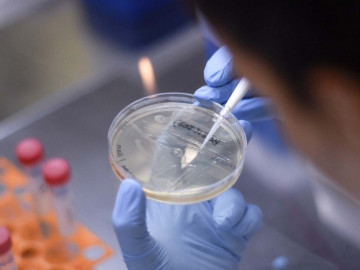
Australia probará vacuna de tuberculosis para combatir coronavirus

Registran en Laredo 22 casos de coronavirus, 18 en Hidalgo y 14 en Cameron
De acuerdo a autoridades oficiales de los 3 condados, hasta el momento, hay un total de 22 casos en el condado de Laredo, 18 en Hidalgo y un total de 14 en Cameron.

De acuerdo a autoridades oficiales de los 3 condados, hasta el momento, hay un total de 22 casos en el condado de Laredo, 18 en Hidalgo y un total de 14 en Cameron.

El conteo oficial a viernes 27 de marzo: 717 casos confirmados, 2,475 casos sospechosos, 3,542 casos negativos y 12 fallecidos.

Estados Unidos es la nación que ha reportado más casos confirmados de COVID-19 en el mundo, con una cifra mayor de 100,000 confirmados, supera a Italia por 20,000 y a China por 15,000.

La directora gerente del Fondo Monetario Internacional (FMI), Kristalina Georgieva, dijo que la economía mundial ha entrado “en recesión, igual o peor que la de 2009”, debido a la pandemia del coronavirus.

A través de un comunicado, el condado Hidalgo, dio a conocer que 7 casos más se registraron, dando positivo a COVID-19, siendo ahora 18 casos, dijo el Juez del condado de Hidalgo Richard Cortez.

El presidente Donald Trump firmó este viernes el histórico plan de rescate de 2 billones de dólares, con el que se busca combatir los efectos de la pandemia del COVID-19 en la economía del país.

Con el fin de apoyar a economía popular ante la emergencia sanitaria por el Covid-19, tal y como lo anunció el presidente Andrés Manuel López Obrador, la Secretaría de Bienestar realiza la dispersión de los recursos de la Pensión para las Personas Adultas Mayores y de las Personas con Discapacidad.

El Fondo Monetario Internacional(FMI), aseguró este viernes que la economía mundial ha entrado en recesión, igual o peor que la del 2009, esto debido a la contingencia de la pandemia del coronavirus que azota a gran parte de la población del planeta.

Las autoridades del Distrito Escolar de Edinburg anunció que, debido a la contingencia de la pandemia del coronavirus, que azota a Estados Unidos y a gran parte de la población mundial, las escuelas permanecerán cerradas, hasta nuevo aviso.

El empresario Bill Gates señaló que "no hay término medio" en la lucha contra el coronavirus y pidió un esfuerzo coordinado para cerrar efectivamente la vida normal en los Estados Unidos para detener la propagación de covid-19 y de esta manera minimizar el largo plazo del Impacto económico.

Las autoridades Sanitarias confirmaron dos nuevos casos de coronavirus en el Condado Hidalgo, por lo que se eleva a 11 el número de casos confirmados del COVID-19.

Este jueves las autoridades Sanitarias confirmaron dos nuevos casos de coronavirus en Laredo Texas, por lo que se eleva a 19 el número de casos confirmados.

De los 10 casos sospechosos al nuevo coronavirus COVID-19 que hasta anoche eran analizados por la Secretaría de Salud de Tamaulipas, 8 fueron negativos, mientras que los 2 restantes se encuentran pendientes de resultados.

La cámara de representantes de Estados Unidos aprobó este viernes paquete de estímulos de 2 billones de dólares con el que se pretende hacer frente a la lucha contra la pandemia del coronavirus que azota fuertemente en la economía del país.

Italia ha vuelto a registrar resultados negativos en su lucha contra la pandemia del coronavirus al confirmar un total de 969 nuevos decesos en las últimas 24 horas, alcanzando un total de 9 mil 134 muertes.

Las autoridades de la ciudad de Laredo y el condado de Webb emitieron una orden de "Estancia en casa / trabajo seguro" que entrará en vigor a las 12:00 am del 28 de marzo de 2020.

Las autoridades del condado emitieron una orden para que los residentes permanezcan en sus hogares al menos por 14 días, esto luego de que se confirmara el primer caso de coronavirus en la ciudad.

Tres niños migrantes que se encuentran bajo custodia de las autoridades de Nueva York, Estados Unidos, dieron positivos a coronavirus.

La noche de ayer, las autoridades Sanitarias confirmaron tres nuevos casos de coronavirus en el Condado Cameron, por lo que se eleva a 13 el número de casos confirmados.

Sube a 17 el número de casos confirmados de coronavirus en Laredo Texas.

El Laboratorio Estatal de Salud Pública analiza 6 nuevos casos sospechosos a COVID-19, corresponden a 4 hombres y 2 mujeres que presentaron síntomas de fiebre, dolor de cabeza, dificultad respiratoria, dolor torácico, de huesos y articulaciones.

El primer ministro de Reino Unido, Boris Johnson, ha anunciado que ha dado positivo en las pruebas del coronavirus, después de presentar "síntomas leves" en las últimas 24 horas.
Un equipo de investigadores australianos, dio a conocer que se decidió probar a gran escala una vacuna utilizada durante décadas contra la tuberculosis para comprobar si puede proteger al personal sanitario del coronavirus.

El Gobierno de Reynosa destinó 60 millones de pesos de las arcas municipales para la creación de un fondo especial para que permita hacer frente a las incidencias causadas por el Covid-19, recursos que serán destinados a programas médicos y económicos, además de descuentos en contribuciones a la ciudadanía.